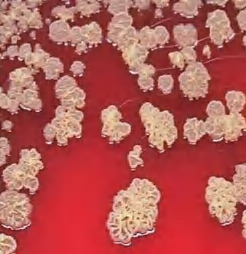
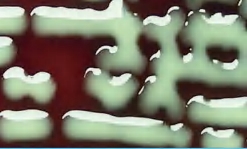
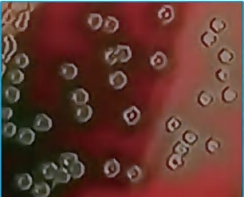
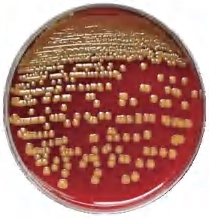
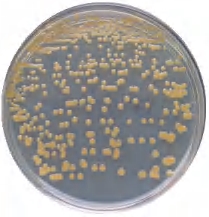
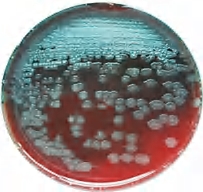
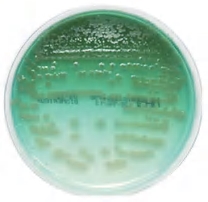
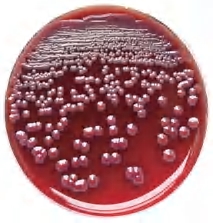
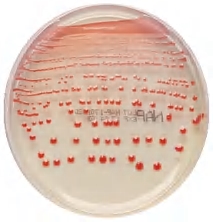
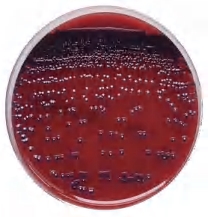
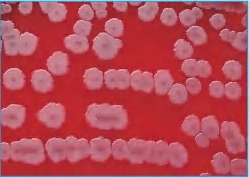
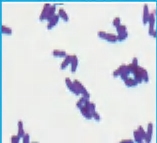
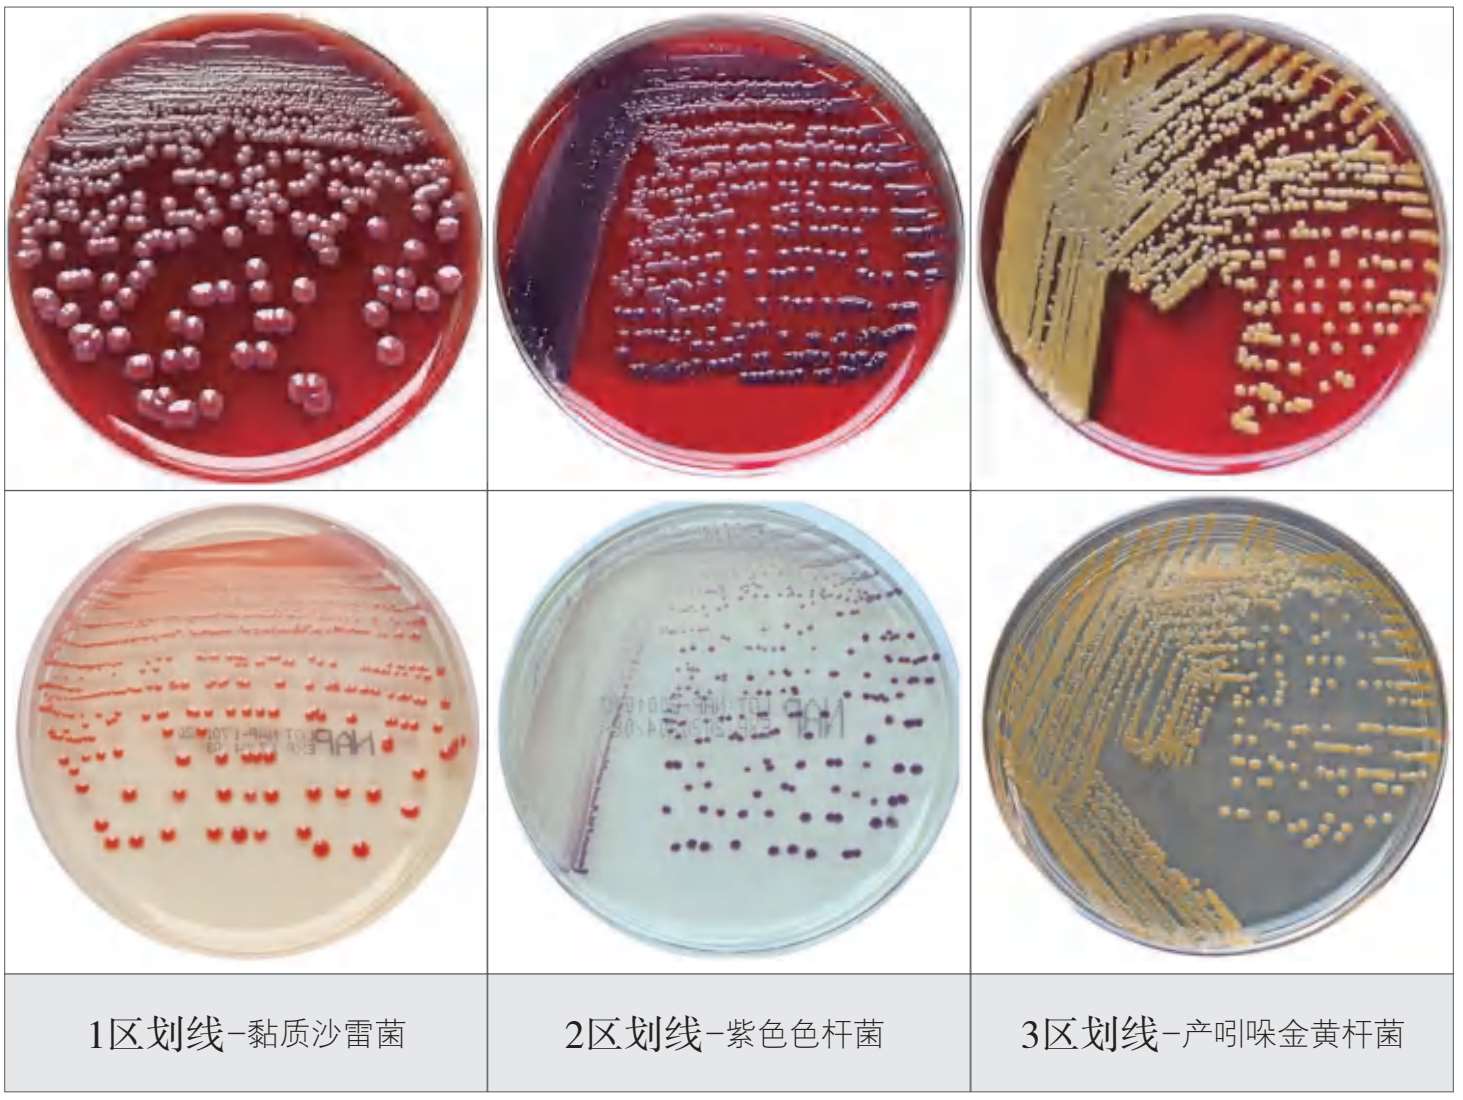

凸起、光滑型(S)-血平板
粗糙型(R)-血平板
黏液型(M)-血平板

扁平-血平板
脐窝状-血平板

碎玻璃样-BCYEα平板

白念珠菌菌落放大照片 ×1000
(可见菌落中的一个个菌细胞)

产吲哚金黄杆菌

铜绿假单胞菌

黏质沙雷菌

紫色色杆菌


藤黄微球菌
注
1.红色平板为哥伦比亚血平板。
2.浅色平板中Mueller-Hinton平板仅接种铜绿假单胞菌,营养琼脂平板接种其他菌株。
3.平板经35℃有氧孵育24~48h。

藤黄微球菌

铜绿假单胞菌

产吲哚金黄杆菌

紫色色杆菌

黏质沙雷菌
注
1.红色平板为哥伦比亚血平板。
2.浅色平板中Mueller-Hinton平板仅接种铜绿假单胞菌,营养琼脂平板接种其他菌株。
3.平板上的菌名用棉签蘸取该菌的培养物手写,经35℃有氧孵育24~48h显示色素特征。

菌落扁平、粗糙、蜡状(35℃)
菌落扁平、湿润、光滑(35℃)

菌落圆形、凸起(55℃)

蜡样芽胞杆菌

枯草芽胞杆菌

嗜热脂肪芽胞杆菌
注 单一菌落为血平板生长物;芽胞染色:石碳酸复红美蓝染色法。
临床意义 蜡样芽胞杆菌广泛存在,因污染淀粉类食品,引起食物中毒,出现恶心、呕吐、腹痛、腹泻,还引起伤口感染和菌血症。枯草芽胞杆菌可引起白血病或肿瘤患者的肺炎、菌血症、脓毒症、伤口感染,以及食源性疾病导致的呕吐、腹泻等。

葡萄球菌

链球菌

双球菌

四联球菌
棒状杆菌

杆菌

弧菌
(菌体弯曲1个)

螺 菌
(菌体弯曲≥2个)

长的菌丝
(诺卡菌)

芽胞
(石碳酸复红美蓝染色)

荚膜
(新型隐球菌墨汁染色)

鞭毛
(改良Ryu染色)

葡萄球菌 0.5~1.5μm

无乳链球菌<2μm

白念珠菌 2~4μm

新型隐球菌(3.0~7.0)×(3.3~7.3)μm
注 形态学观察可以简便区别两类不同的菌种 ×1000

注
1.红色的平板为哥伦比亚血平板。
2.浅色平板中的Mueller-Hinton 平板仅接种铜绿假单胞菌,营养琼脂平板接种其他菌株。
3.全自动微生物接种仪型号:PREVI ISOLA. AS 180。
注
1.红色为哥伦比亚血平板。
2.浅色为营养琼脂平板。
3.平板35℃有氧孵育48h。
4.接种细菌:产不同色素细菌。